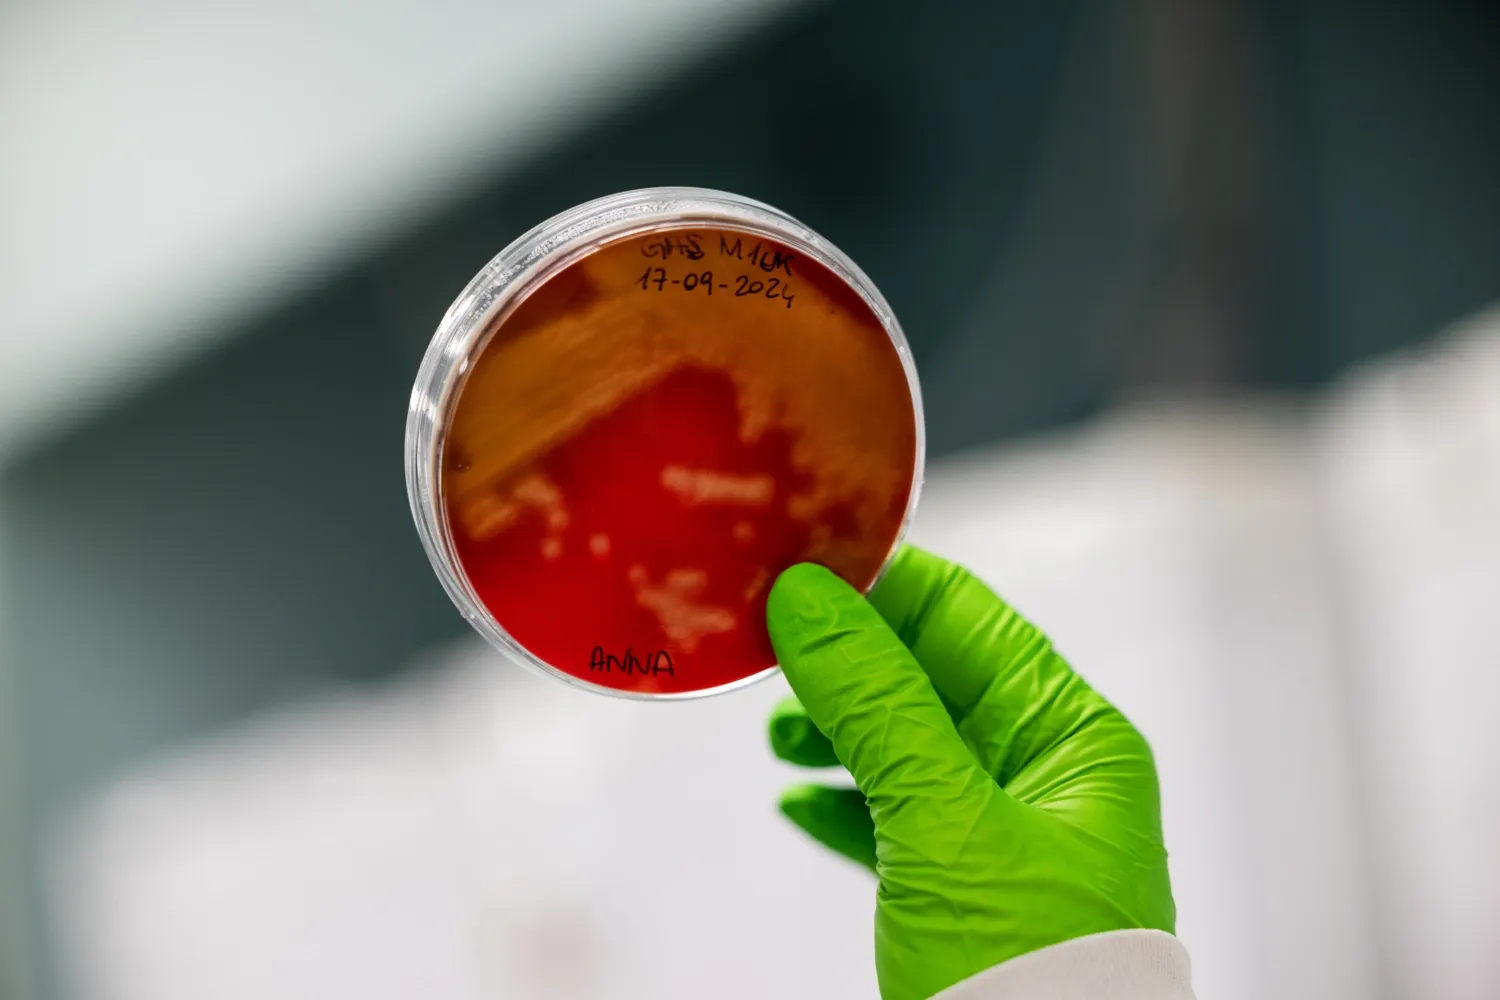
Karolinska Institutet

Forskning vid institutionen för medicin, Huddinge
Vid institutionen för medicin, Huddinge (MedH) bedrivs såväl klinisk forskning som grundforskning inom ett stort antal områden som en följd av den bredd som finns representerad inom de olika medicinska specialiteterna. Institutionen är även värd för sex core faciliteter vid KI Campus Flemingsberg.
Meny för detta område
Avdelningar vid institutionen för medicin, Huddinge
Foto: Liza Simonsson
Foto: Liza SimonssonCentrum för infektionsmedicin
Forskningen vid Centrum för infektionsmedicin (CIM) fokuserar på studier av människans immunsystem, samt den roll immunsystemet spelar vid infektionssjukdomar.
 Foto: iStock
Foto: iStockCentrum för reproduktion, metabolism och molekylär medicin
Vid avdelningen studerar vi brett ett flertal områden med syfte att utveckla nya behandlingar mot vanliga folksjukdomar såsom övervikt/obesitas, diabetes, blodfettsrubbningar, infertilitet och neurodegenerativa tillstånd.
 Foto: Getty Images
Foto: Getty ImagesGastroenterologi och nutrition
Forskningen vid avdelningen GUT fokuserar främst på leversjukdomar, nutrition och metabolism samt genreglering. Vårt arbete sträcker sig från grundläggande molekylärvetenskap till translationell forskning, epidemiologi, patientcentrerade och kliniska studier samt sjukdomsprevention.
 Foto: cc Pixabay,Public domain CC0
Foto: cc Pixabay,Public domain CC0Hematologi/Centrum för hematologi och regenerativ medicin
Avdelningens uppdrag är att förena framstående klinisk vård och forskning i en translationell miljö. Här finns ett nära samarbete mellan grupper inom grundläggande, translationell och klinisk forskning. Majoriteten av forskargrupperna är verksamma vid Centrum för hematologi och regenerativ medicin (HERM) i Neo, KI Campus Flemingsberg.
 Foto: Pixabay
Foto: PixabayIntegrativ kardiovaskulär, cancer- och åldrandeforskning
Forskningen vid avdelningen fokuserar bl a på vetenskaplig utvärdering och utveckling av pågående diagnos och behandling, samt utveckling av ny mekanistisk kunskap, diagnos- och behandlingsmetoder inom hjärt- och lungsjukdomar.
 Foto: N/A
Foto: N/AStöd vår forskning
Institutionen för medicin, Huddinge välkomnar stora som små gåvor för att stödja medicinsk forskning och utbildning. Ditt bidrag gör stor skillnad och tillsammans kan vi komma längre i vårt arbete med att förbättra människors hälsa.
 Foto: Pixabay
Foto: PixabayPublikationer från institutionen för medicin, Huddinge
Här kan du söka fram alla verifierade publikationer från forskare vid institutionen för medicin, Huddinge.
 Foto: Erik Cronberg
Foto: Erik CronbergDoktorsavhandlingar från institutionen för medicin, Huddinge
Här hittar du doktorsavhandlingar från institutionen för medicin, Huddinge.
 Foto: Peter Holgersson
Foto: Peter HolgerssonMedH core faciliteter
Institutionen för medicin, Huddinge är värd för tre core faciliteter på KI Campus Flemingsberg.
